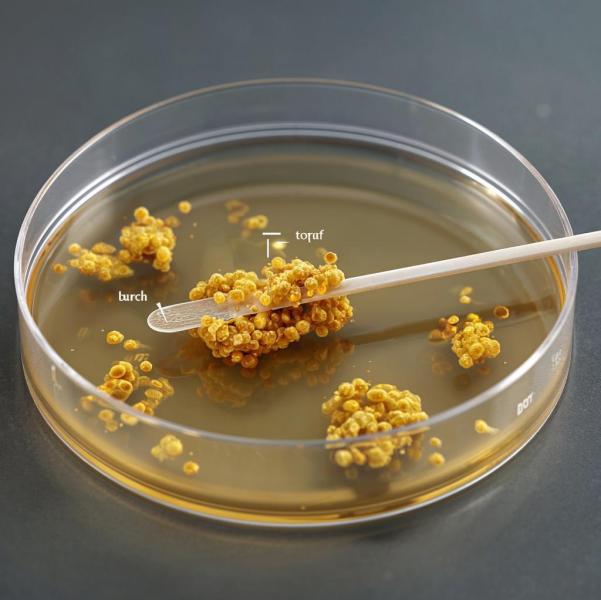

Лечение золотистого стафилококка: когда нужно лечить инфекцию
▌ Стафилококковая инфекция: показания к терапии
Золотистый стафилококк (Staphylococcus aureus) является условно-патогенным микроорганизмом, который обнаруживается в мазках слизистых оболочках человека/кожном покрове.Присутствие бактерии само по себе 💭не требует обязательного лечения, поскольку она входит в состав нормальной микрофлоры организма большинства здоровых взрослых и детей.
💊Однако существуют ситуации, когда терапия необходима:
- Клинические проявления инфекции: наличие гнойничковых заболеваний кожи, фурункулеза, маститов, ангины, бронхитов, пневмоний и др.;
- Профессиональные требования: работа в сфере общественного питания, медицинских учреждениях и детских коллективах обязывает поддерживать санитарно-эпидемиологическое благополучие путем санации носителей патогенных штаммов бактерий.
В РФ 🇷🇺 , лицам, работающим на пищеблоках, рекомендовано профилактическое лечение золотистого стафилококка даже при бессимптомном носительстве, чтобы исключить риск распространения возбудителя среди населения.
#лор #лечение #мазки #бактерии #новосибирск
Комментарии
Здравствуйте! Мазки лучше сдавать после осмотра врача,так как это не рутинная история. Картина мазка может быть не информативна/стерта из-за недавней болезни/насморка на момент осмотра или использования какого-то спрея.
Если решили сдавать самостоятельно,то можно сдать обычный бак.посев на микрофлору. Но для меня есть нюанс: уточняйте в лаборатории,чтобы указывали титр того,что выявляли. Часто стала сталкиваться с тем,что приходит результат (выявлена условно-патогенная Флора) и никакой конкретики более. Тогда вообще не понятно,что вы искали и что хотели далее делать по результату этого мазка.
Прицельные мазки на стафилококк сдаются только в случае подозрения на конкретное заболевание.

Здравствуйте, подскажите, пожалуйста, какой анализ информативнее сдать на стафилококк при заболеваниях ЛОР части (в том году гаймориты, в этом- ПТА)?